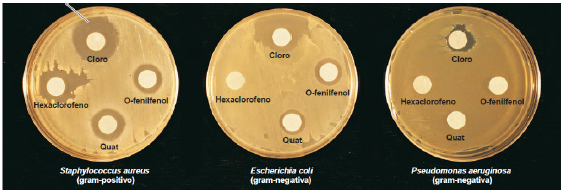
Enunciado 3362828-1

Foram encontradas 50 questões.
Num laboratório de Biotecnologia, um técnico avaliou a ação de quatro desinfetantes pelo método de difusão em disco: cloro, hexaclorofeno, o-fenilfenol e quartenário de amônio (“Quat”). Nestes ensaios, o técnico avaliou a ação dos desinfetantes em três bactérias, Staphylococcus aureus, Escherichia coli e Pseudomomas aeruginosa, classificadas como gram-positivo, gram-negativa e gram-negativa, respectivamente. Após 24 h, foram observados os resultados, as placas de Petri foram fotografadas e estão apresentadas na Figura 1.
Figura 1: Resultados da avaliação de 4 (quatro) desinfetantes pelo método de disco-difusão conduzido usando três bactérias diferentes.
Fonte: Tortora, G. J.; Funke, B. R.; Case, C. L. Microbiologia, Décima edição,
Editora Artmed, 2012.
Com base no resultado obtido e apresentado na Figura 1, qual alternativa possui análise correta dos resultados obtidos por este método de disco-difusão realizado para avaliar a ação desinfetantes nos compostos avaliados?
Provas
O laboratório é um lugar propicio para acontecer vários acidentes por vários motivos como, por exemplo, por descuido, descaso, pressa, ou condições inadequadas de trabalho.
Marque a alternativa que apresenta primeiros-socorros que devem ser prestados,caso algum acidente ocorra.
Provas
Devido ao tamanho dos micro-organismos, estes organismos não podem ser vistos a olho nu, devendo ser observados através de um microscópio.
Correlacione o nome do microscópio à sua característica.
1 - Microscópio óptico composto
2 - Microscópio de campo escuro
3 - Microscópio de varredura por sonda
4 - Microscópio de fluorescência
A - Microscópio que contém um artefato para dispersar a luz, de forma que o espécime aparece claro em um fundo escuro.
B - Microscópio que é utilizado para se obter imagens de formas moleculares, caracterizar propriedades químicas e determinar variações de temperatura dentro de um espécime.
C - Microscópio que utiliza uma fonte de luz ultravioleta para iluminar espécimes que irão fluorescer.
D - Microscópio com dois grupos de lentes que usa a luz visível como fonte de iluminação.
Provas
O meio de cultivo utilizado num processo biotecnológico é um dos fatores importantes a ser avaliado.
Sobre meio de cultivo, é correto afirmar que:
Provas
Para o isolamento de uma cultura por espalhamento, o método que deve ser realizado é:
Provas
A respeito das técnicas de coleta, preservação e análise de amostras, assinale a alternativa correta.
Provas
O planejamento de programas de amostragem no meio ambiente é algo fundamental, sendo a etapa de amostragem necessária à caracterização do meio a ser estudado, e desta etapa dependem todas as etapas subsequentes.
Qual afirmativa apresenta uma etapa que faz parte do planejamento de amostragem?
Provas
Em caso de acidentes com derramamento de substâncias no laboratório, é necessário agir rápido e deve-se isolar e conter a área. Em seguida é indicado fazer tratamento da área afetada para posterior limpeza, a qual deve ser realizada com luvas resistentes e proteção individual.
I - Os acidentes com substâncias ou produtos ácidos de origem mineral ou orgânica devem ser tratados com produtos que os neutralizem e os solidifiquem em sais para facilitar a limpeza.
II - Os acidentes com produtos cáusticos devem ser tratados com ácidos fortes, por exemplo, ácido clorídrico, que funcionam como neutralizantes e solidificantes, transformando-os em sais fáceis de limpar e descartar corretamente.
III - Em caso de acidentes com solventes, por exemplo, pode ser tratado com material carbonáceo, que adsorve muitos solventes líquidos e fluidos combustíveis, aumentando a vaporização. Este procedimento não é recomendado, por exemplo, para peróxidos orgânicos e componentes de hidrazina.
Sobre a etapa de tratamento, é correto o que se afirma em:
Provas
Em um laboratório é importante saber interpretar todos os avisos fixados na parte física destes, em equipamentos e em frascos de reagentes, sendo utilizado para pictogramas.
Considerando as seguintes imagens, marque a alternativa que indica o significado correto destes pictogramas.

Provas
Os equipamentos e dispositivos de proteção coletiva têm por finalidade garantir a integridade física das pessoas que trabalham ou circulam num laboratório, evitando acidentes.
Marque a alternativa que apresenta apenas equipamentos e dispositivos de proteção coletiva.
Provas
Caderno Container